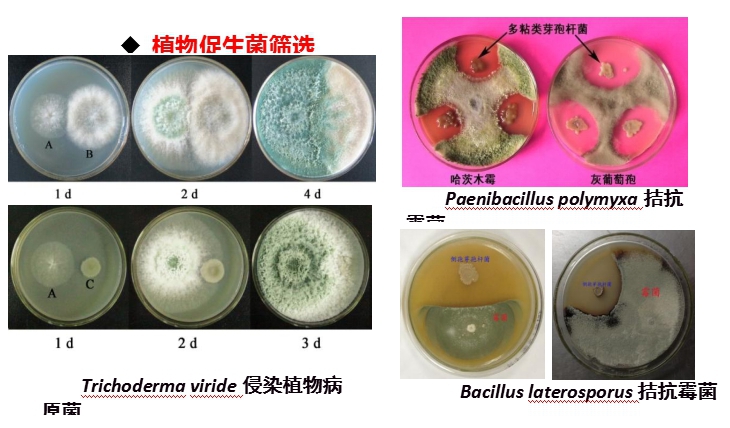

生物技術(shù)在畜禽糞污處理與資源化利用方面的應(yīng)用
- 作者:
- 安徽新天源建設(shè)咨詢有限公司
- 最后修訂:
- 2020-07-04 09:19:50
摘要:
目錄
【簡介】
畜禽養(yǎng)殖業(yè)是我國農(nóng)業(yè)和農(nóng)村經(jīng)濟(jì)的重要組成部分,畜禽養(yǎng)殖業(yè)大力發(fā)展所帶來的環(huán)境污染問題日益嚴(yán)重,不僅影響經(jīng)濟(jì)發(fā)展, 而且還危及生態(tài)安全,已成為人們普遍關(guān)注的社會問題。畜禽養(yǎng)殖場產(chǎn)生的糞便和污水造成地表水、地下水、土壤和環(huán)境空氣的嚴(yán)重污染,直接影響了人們的身體健康和正常生產(chǎn)生活。畜禽養(yǎng)殖場未經(jīng)處理的高濃度有機(jī)廢水直接排入或隨雨水沖刷進(jìn)入江河湖庫,大量消耗水體中的溶解氧,使水體變黑發(fā)臭,嚴(yán)重者導(dǎo)致魚塘及河流喪失使用功能。養(yǎng)殖污水長時(shí)間滲入地下,使地下水中的硝態(tài)氮或亞硝態(tài)氮濃度增高,有毒成分增多,導(dǎo)致水質(zhì)惡化,同時(shí)危及周邊生活用水水質(zhì)。高濃度污水還可導(dǎo)致土壤孔隙堵塞,造成土壤透氣、透水性下降及板結(jié)、鹽化,嚴(yán)重降低土壤質(zhì)量,甚至傷害農(nóng)作物,造成減產(chǎn)和死亡。因此,如何科學(xué)地處理畜禽養(yǎng)殖業(yè)糞污污染是當(dāng)前養(yǎng)殖管理者亟待解決的問題。
【主持人致辭】
劉全友:各位領(lǐng)導(dǎo)、各位專家、各位同事大家上午好!今天沙龍的主題是“生物技術(shù)在畜禽糞污處理與資源化利用方面的應(yīng)用”。在開始之前,我先說兩點(diǎn):一是原計(jì)劃中心領(lǐng)導(dǎo)莊續(xù)亮研究員要來參加活動(dòng),主旨報(bào)告人為徐圣君研究員,但由于有其他重要活動(dòng),他們均不能參加此活動(dòng),在此特向大家表示歉意,并邀請白志輝研究員來作主旨報(bào)告。二是今天有幸請到了院老科協(xié)領(lǐng)導(dǎo)、環(huán)境部、農(nóng)業(yè)部規(guī)劃院領(lǐng)導(dǎo)、高等院校教授、以及企業(yè)領(lǐng)導(dǎo)及專家指導(dǎo)此活動(dòng),在此我們表示誠摯的歡迎和感謝!
如何科學(xué)地處理畜禽養(yǎng)殖業(yè)糞污是當(dāng)前養(yǎng)殖管理者、政府以及科技界亟待解決的問題。
國內(nèi)外中小型及規(guī)?;笄蒺B(yǎng)殖場現(xiàn)行的主要清糞工藝有水沖糞、水泡糞和干清糞工藝,即多為物理法為主。以養(yǎng)豬業(yè)為代表的畜禽養(yǎng)殖廢水具有排放量大、沖擊負(fù)荷大,固液混雜,有機(jī)質(zhì)濃度高,含氮量高,碳氮比失調(diào),處理難度大等特點(diǎn)。
而針對我國規(guī)?;B(yǎng)殖場來說,近些年來大多采用固液分離—厭氧發(fā)酵—好氧曝氣傳統(tǒng)三段式工業(yè)處理模式處理養(yǎng)殖廢水,即理、化并用技術(shù)。該處理模式具有占地小、季節(jié)適應(yīng)性強(qiáng)以及可產(chǎn)出部分能源氣體(沼氣)等優(yōu)點(diǎn)。但同時(shí)也存在投入、運(yùn)行成本高,有機(jī)物和氮的去除不徹底,除磷工藝缺乏等缺點(diǎn)。隨著《畜禽養(yǎng)殖業(yè)污染物排放標(biāo)準(zhǔn)》(征求意見稿)的逐步落實(shí),現(xiàn)行的畜禽養(yǎng)殖廢水處理工藝大多已無法滿足新標(biāo)準(zhǔn)的排放要求。
當(dāng)前,根據(jù)科技的發(fā)展及要求,中科院生態(tài)環(huán)境研究中心團(tuán)隊(duì)通過菌種培養(yǎng)等技術(shù),逐漸形成了“農(nóng)業(yè)種、養(yǎng)、加廢棄物高值化利用”的技術(shù)思路。即物、化、生集成技術(shù)模式。從源頭上減控養(yǎng)殖糞污中污染物向環(huán)境中的排放量;通過施加纖維素降解菌、多粘類芽孢桿菌以及類球紅細(xì)菌等植物促生菌強(qiáng)化秸稈、畜禽糞便和廢水中有機(jī)質(zhì)、氮、磷等“污染物”進(jìn)行高效生物轉(zhuǎn)化,為農(nóng)作物的生長提供必需的養(yǎng)分,提高農(nóng)作物的產(chǎn)量;養(yǎng)殖糞污中的營養(yǎng)物質(zhì)經(jīng)過處理加工成生物有機(jī)肥、植物促生菌劑和水體修復(fù)劑等產(chǎn)品,實(shí)現(xiàn)綜合利用,且具有在大型養(yǎng)殖場試驗(yàn)成功的案例。
下面有請白志輝研究員作報(bào)告,大家歡迎!
【主旨報(bào)告】
白志輝:生物技術(shù)在畜禽糞污處理與資源化利用方面的應(yīng)用
非常感謝老科協(xié)給我們這個(gè)機(jī)會?,F(xiàn)跟各位老師匯報(bào)一下我們最近的研究思路和科研進(jìn)展,希望給予指點(diǎn)。
今天主要匯報(bào)四個(gè)方面的內(nèi)容,首先介紹背景情況。近些年來,咱們國家對環(huán)保問題越來越重視,尤其是習(xí)總書記提出生態(tài)文明建設(shè),講綠水青山,綠色發(fā)展成為我國重要國策。從2013年以來,國家出臺了系列的污染治理的行動(dòng)方案,包括水十條、土十條、氣十條,標(biāo)志著國家對于環(huán)境保護(hù)工作的重視程度。從國家層面、社會層面也都越來越重視,也是在發(fā)展階段,問題特別突出。
因?yàn)檫@個(gè)題目主要是畜禽養(yǎng)殖方面的污染治理,或者廢棄物的資源化利用,國家和地方都相應(yīng)出臺了很多措施。因污染確實(shí)比較大,到目前為止,把很多污染難以治理的小型企業(yè)關(guān)停了。但還有一些規(guī)模比較大,可以做規(guī)范化治理的還保留著,新增養(yǎng)殖場相對來說更規(guī)范了一些,也是因?yàn)榍捌谟幸恍┘夹g(shù)的研發(fā)和政策的鋪墊。但目前還是存量的問題。
畜禽養(yǎng)殖的問題,對水污染影響比較大。流域的水污染也是做了很多年,包括國家科技方面的重大專項(xiàng),對污染的情況做了很好的總結(jié),現(xiàn)在基本上都是收尾階段了。因?yàn)槊嬖次廴?,?shí)際上是流域污染的一個(gè)最重要的來源。點(diǎn)源,基本上管理的越來越到位了,但面源,仍然是壓力巨大。
面源污染主要是不太好管理,技術(shù)方面,相對來說還有一些欠缺。 像畜禽養(yǎng)殖,這對農(nóng)業(yè)面源貢獻(xiàn)比較大的,每年畜禽糞污有30多億噸的產(chǎn)出量。
另外,農(nóng)業(yè)污染還有一些農(nóng)產(chǎn)品加工的高濃度的廢水、廢渣之類的,實(shí)際上完全是放錯(cuò)了地方的資源。因?yàn)檫@個(gè)作為污染物來處理,它濃度都特別大,成本特別高,很難把它處理達(dá)標(biāo)排放,這里有很多的氮、磷以及有機(jī)質(zhì)資源。在這方面,還是以資源化利用為主比較好。
現(xiàn)在對養(yǎng)殖糞污的處理技術(shù)做一個(gè)簡要的介紹。
像日本,歐美的一些國家,他們相對來說管理規(guī)范一些,沼氣發(fā)酵、農(nóng)用這些方面相對做的比較好。包括德國,相當(dāng)于沼氣發(fā)酵完了,剩下的廢棄物作為農(nóng)業(yè)應(yīng)用,生態(tài)農(nóng)業(yè)也做得比較好。但我國的規(guī)模實(shí)在是太大了,小型的養(yǎng)殖場,就不怎么處理就直接排放,而現(xiàn)在基本都關(guān)停了,這是管理方面的一個(gè)進(jìn)步。
但大型養(yǎng)殖場,由于在建設(shè)期,沒有考慮到環(huán)境容量,目前還是以污染治理的方式來進(jìn)行糞污的處理。
我國現(xiàn)行的行業(yè)標(biāo)準(zhǔn),畜禽養(yǎng)殖方面的污水排放標(biāo)準(zhǔn),COD為400mg/L,氨氮為80mg/L,實(shí)際上這個(gè)排放標(biāo)準(zhǔn)太松了。但即便這么松,達(dá)標(biāo)也很難。目前他們能承受的價(jià)格,一噸污水5到50元,達(dá)到現(xiàn)行標(biāo)準(zhǔn)就比較難。那么,達(dá)標(biāo)后的廢水污染程度還是很嚴(yán)重的,其污染物濃度都比城市的生活污水不經(jīng)過處理直接排放的濃度還高。所以,即將出臺的新標(biāo)準(zhǔn)提高了,相對地表水來講,還是污染濃度太高,COD、氨氮、總磷都是這個(gè)指標(biāo),即便提高了標(biāo)準(zhǔn),還是比地表水高得多,實(shí)屬嚴(yán)重污染。
所以,達(dá)標(biāo)排放的這個(gè)方案,實(shí)際上也是一個(gè)沒辦法的辦法,比起不處理,起碼90%以上的污染物能去除掉了。達(dá)標(biāo)排放的思路,只能說是一個(gè)臨時(shí)的措施,就是技術(shù)模式問題,即治理思路要轉(zhuǎn)變。
目前,畜禽養(yǎng)殖行業(yè)的技術(shù)需求這個(gè)環(huán)節(jié),主要是因?yàn)榧S污里的氮磷以及有機(jī)物濃度很大,包括排放量也很大。處理成本高,得不償失。那么,這個(gè)農(nóng)業(yè)過程,也是生態(tài)農(nóng)業(yè),這些都是很好的肥料。但以前規(guī)模小的時(shí)候,實(shí)際上滿足不了土地對肥料的需求,顯得沒有什么污染,就當(dāng)作為簡單的堆肥使用就行了。
但目前,養(yǎng)殖的規(guī)模太大,污染物排放特別集中,當(dāng)時(shí)建廠的時(shí)候,也沒有涉及到周邊環(huán)境的容量問題,或者考慮的不周全,所以,必須做一個(gè)治理。但在治理過程中,我們還是想著讓這些污染物,或者營養(yǎng)物,通過技術(shù)改變,還是能讓它盡量的循環(huán)起來,用于農(nóng)業(yè)或者是林業(yè),把這些營養(yǎng)資源利用起來,也就替代這個(gè)污染達(dá)標(biāo)排放的思路了。
從整體上來講,我國的農(nóng)田,包括林、草,這些氮磷的需求,對于一定的土地面積,是完全可以消納這些養(yǎng)殖排放的營養(yǎng)物的,只是結(jié)構(gòu)不合理罷了。
在結(jié)構(gòu)不合理的情況下,相對來說,資源化技術(shù)還是不能滿足需求的?,F(xiàn)在,我們在農(nóng)業(yè)的種、養(yǎng)、加的廢棄物資源化利用方面,已開展了很多年,也得到了國家很多項(xiàng)目的支持。
這個(gè)主要還是從一些功能菌劑、做肥料、肥料應(yīng)用等幾個(gè)方面來開展工作。源頭,主要是以生物技術(shù)為主,咱們院重點(diǎn)實(shí)驗(yàn)室,把這個(gè)廢棄物通過生物轉(zhuǎn)化來變成更適合應(yīng)用的一些產(chǎn)品,主要是篩選很多植物促生菌,微生物肥料的功能菌,幫助植物吸收利用這些養(yǎng)分。
然后,我們也用這些廢棄物,做了一些其它方面的環(huán)境修復(fù)的微生物菌劑,包括農(nóng)藥的分解,水產(chǎn)養(yǎng)殖改善這些菌劑,盡量的把廢棄物轉(zhuǎn)化成相對功能強(qiáng)一點(diǎn)的,或者說應(yīng)用價(jià)值高一點(diǎn)的產(chǎn)品,可能對這些廢棄物在有限的環(huán)境容量范圍內(nèi),往更廣闊的區(qū)域使用,這些污染物的消納,就會有足夠的空間。
技術(shù)模式的一種,就是我們用的異位發(fā)酵床,配合養(yǎng)殖場,把糞污用發(fā)酵床的方式,相當(dāng)于集約化的有機(jī)肥,消納更多一些,少用填料,多消納廢棄物,這種模式是我們在生物技術(shù)方面的一個(gè)改良,主要還是把功能,就是對植物生長,或者是糞污分解轉(zhuǎn)化,功能比較強(qiáng)的一些微生物的制劑,應(yīng)用到發(fā)酵過程中,并提高這個(gè)發(fā)酵的效率。
另一方面,液體的廢棄物,廢水,濃度很高,基本上發(fā)酵床還是以高濃度或者說這個(gè)類似于固體的這種工業(yè)分離以后,更高濃度的廢水消納更好,這是農(nóng)業(yè)部基本定型的。首先是要有一個(gè)沼氣發(fā)酵,發(fā)酵后,起碼是利用一些碳源作為清潔能源,然后糞污里的病源微生物,有害的東西分解一些,有機(jī)物少了一些。但氮磷基本上大部分在里頭,直接排放肯定是不允許的,我們采取了一些濕地的技術(shù),就是用這些沼液廢水種水生植物,包括目前做得比較多的是綠狐尾藻。我們和亞熱帶生態(tài)研究所一起做的,這個(gè)綠狐尾藻生長的特別快,能耐受高氨氮濃度。一般的植物,耐受性很差的生長得不好,而綠狐尾藻對氨氮的耐受性很好,它生長量特別大。在這種實(shí)際系統(tǒng)里,相當(dāng)于它的生物量,以蛋白質(zhì)來算,一畝綠狐尾藻,每年的產(chǎn)量相當(dāng)于種玉米蛋白質(zhì)產(chǎn)量的10倍。所以它對氨氮的吸收利用是很有優(yōu)勢的植物,這個(gè)綠狐尾藻也是可以作飼料開發(fā)的。
因?yàn)闈竦叵到y(tǒng)的水還是要排放的,為了讓它達(dá)標(biāo)排放,如果空間有限的話,還是要把這個(gè)污染物盡量多的給它去除。所以,我們又研發(fā)了一種叫綠狐尾藻+生物膜的強(qiáng)化型濕地模式,水體表面有綠狐尾藻的生長,水里還有微生物的一些強(qiáng)化,這樣對污染物的去除,有更好的幫助。
經(jīng)濕地處理以后,可以達(dá)到地表水的,接近地表水的這個(gè)排放水質(zhì),便有了水的使用功能,這是剛才介紹的綠狐尾藻+微生物膜的技術(shù)。
現(xiàn)在對異位發(fā)酵床作詳細(xì)的介紹。我們主要也是用了一些功能菌劑,包括一些芽孢桿菌,它在發(fā)酵階段,對發(fā)酵能力的提升和污染物的降解,也起到相互促進(jìn)的作用。污染物降解得快,提升也高,這種芽孢桿菌在六七十度的時(shí)候還可以非?;钴S的在發(fā)酵床里代謝,這是它在發(fā)酵床的優(yōu)勢。
在此病源微生物、大腸桿菌、草籽這些會死掉。但芽孢桿菌這些還很活躍,這是發(fā)酵床強(qiáng)化的一個(gè)方面。我們篩選的植物促生菌,簡單說就是幫助植物生長的菌,提高氮磷的吸收,還有一些植物的激素,植物促生菌,有很多方面的功能,這都是有專利的菌。
這相當(dāng)于是介紹的狐尾藻系統(tǒng)處理的養(yǎng)殖廢水,包括這些養(yǎng)殖廢水,以及一些現(xiàn)在工業(yè)化處理的尾水達(dá)標(biāo)排放,實(shí)際上達(dá)標(biāo)排放的污染物濃度依然很高,再用濕地系統(tǒng)深度凈化,達(dá)到地表水的要求,這里處理的指標(biāo),對氨氮的去除有很好的提升作用,在這個(gè)過程中,生物量相對其它植物來講還是很大,就是說對這個(gè)營養(yǎng)物的利用能力比較高。
在這個(gè)系統(tǒng)里,生物強(qiáng)化這塊,主要是用一些功能微生物菌劑來強(qiáng)化系統(tǒng),比如說農(nóng)產(chǎn)品加工的廢水,來作為它的生產(chǎn)原料,也是消納這個(gè)污染物的同時(shí),生產(chǎn)了一些環(huán)境友好的產(chǎn)品,這些菌劑又反過來強(qiáng)化污染物的轉(zhuǎn)化,也是另外的一個(gè)廢棄物,或者說是廢水資源化的思路。
這是一些用功能微生物菌劑添加到發(fā)酵過的畜禽糞污,或者含有生物質(zhì)廢棄物的發(fā)酵系統(tǒng)里。這個(gè)微生物肥料的產(chǎn)品,還是都符合農(nóng)業(yè)部的這些產(chǎn)品的質(zhì)量要求的,而且功能性比較好。

徐圣君博士以前在長沙做過用植物促生菌的菌劑來處理茶園的實(shí)驗(yàn)。提高茶葉的品質(zhì)或產(chǎn)量的同時(shí),還有在農(nóng)田土壤里,對污染物的排放有一個(gè)非常好的控制。后面還有其它的實(shí)驗(yàn)結(jié)果,這些功能菌劑,在水產(chǎn)養(yǎng)殖方面也有一些使用。因?yàn)橘Y源化的產(chǎn)品,使用面兒越廣,廢棄物的資源化利用才有出路。所以,我們也是從微生物制劑的產(chǎn)品方面研發(fā)。水產(chǎn)養(yǎng)殖過程中,水質(zhì)是影響水產(chǎn)品產(chǎn)量、品質(zhì)的一個(gè)非常重要的指標(biāo)。但養(yǎng)殖池塘里的水質(zhì),也是因?yàn)橥斗诺娘暳稀⑺鷦?dòng)物的糞便,引起的富營養(yǎng)化很明顯,通過菌劑的改善,對于水產(chǎn)養(yǎng)殖也有一個(gè)很好的提升與用途。
以前,在大港油田,用廢棄物生產(chǎn)的微生物產(chǎn)品,用于石油污染土壤的修復(fù)。大港油田不僅僅是石油污染,而且還是鹽堿地。當(dāng)時(shí)是863項(xiàng)目,本來設(shè)計(jì)的是用植物、微生物聯(lián)合修復(fù)的石油污染土壤,但它鹽堿很重,植物不能生長。所以,用微生物制劑,提高石油分解的過程中,也把鹽堿地改良了,也做了生物技術(shù)方面的一些應(yīng)用。說明了石油污染土壤的修復(fù),用微生物的方法并不難,效果還挺好,但鹽堿地的改良,時(shí)間花了很長。
在茶園里用微生物肥料,對土壤的污染排放控制,像南方,用氮肥以后,下雨有淋濕,把農(nóng)田的面源污染淋濕到水體里,富營養(yǎng)化了。那么,還有溫室氣體來替代化肥,就會得到很好的控制。這不僅是農(nóng)產(chǎn)品品質(zhì)和產(chǎn)量的提升,經(jīng)濟(jì)效應(yīng)、環(huán)境效益也得到顯著提升。
在狐尾藻做飼料工作這方面,目前也有比較好的前景。
下面講的是畜禽養(yǎng)殖污水應(yīng)用技術(shù)的情況,第一個(gè)模式,高濃度的污水常規(guī)生物處理系統(tǒng),目前用得比較多的,沼氣發(fā)酵完了以后,沼液通過AO工藝也好,或者一些比較長的工藝路線,做到達(dá)標(biāo)排放。但實(shí)際上污染還是太重,處理的成本太高。即后面的這個(gè)模式,盡量的使這些營養(yǎng)物作為資源化回收,即沼液和狐尾藻的一個(gè)模式。
再一個(gè),因?yàn)榉N狐尾藻的濕地系統(tǒng),還是要有土地面積的,面積小了,排放過于集中,狐尾藻的系統(tǒng)也消納不了。消納不了的話,第三個(gè)模式,折中一下,把常規(guī)的污水處理系統(tǒng)和這個(gè)資源化的技術(shù)在這個(gè)有條件的地方進(jìn)行組合,即按一萬頭豬的承載量規(guī)模來做概算,也是很多企業(yè)一直在推廣、使用的一些養(yǎng)殖污染治理的技術(shù)。
過程中,對一些造價(jià)、成本進(jìn)行核算,這是三種模式的情況。因地制宜,有土地,有環(huán)境容量,它資源化利用率就高一些。如沒有地方,那就處理得讓它盡量達(dá)標(biāo)好了。
介紹一些典型的案例。這是相當(dāng)于是狐尾藻和微生物膜的生態(tài)濕地相結(jié)合,一個(gè)是讓它能水質(zhì)改善,再一個(gè)是能回收一些狐尾藻飼料化的一些產(chǎn)品,這種折中的方法,進(jìn)水出水的效果還是比較顯著的,達(dá)標(biāo)是肯定沒有問題。但是,土地資源有限的情況下,它離地表水的標(biāo)準(zhǔn)還有一定距離。
用狐尾藻和生物膜系統(tǒng),除了養(yǎng)殖廢水,還有河道治理也有應(yīng)用。河道水體的污染程度要比養(yǎng)殖廢水低得多。所以,對水的改善,效果應(yīng)該更好一些,從劣V類提高到Ⅲ類Ⅳ類,都能實(shí)現(xiàn)。
這些已獲如中國科學(xué)院科研團(tuán)隊(duì)科技成果轉(zhuǎn)化獎(jiǎng)一等獎(jiǎng),北京市科學(xué)技術(shù)獎(jiǎng)一等獎(jiǎng)等。
大型的示范工程,是在中科院有一個(gè)農(nóng)業(yè)環(huán)境監(jiān)測站,和當(dāng)?shù)仄髽I(yè)一起做的。在金井流域,整個(gè)一個(gè)小流域的治理,養(yǎng)殖、農(nóng)產(chǎn)品加工、種植,治理強(qiáng)度還蠻高,然后污染物的排放,點(diǎn)源面源都有。
在這個(gè)流域治理過程中,包括了養(yǎng)殖的這些糞污的消納,也包括了農(nóng)產(chǎn)品加工的廢水和廢棄物的一些資源化。也包括農(nóng)業(yè)的種植模式的改善,也是把這些廢棄物的微生物肥料的產(chǎn)品,在種植過程中,進(jìn)行一些推廣應(yīng)用,從源頭,可以消減面源的一些排放,有一個(gè)很好的消減率,實(shí)際上面源污染控制,從源頭減排,還是最關(guān)鍵的環(huán)節(jié)。
通過前面介紹工作,也啟發(fā)了后面解決農(nóng)業(yè)或養(yǎng)殖污染問題,做一些思考。這個(gè)思路,也跟目前咱們國家,包括農(nóng)業(yè)部、環(huán)保部,推行的政策都是非常吻合的。
現(xiàn)在農(nóng)業(yè)部也有糞污、做肥料方面的一些試點(diǎn),因?yàn)榧S污治理是個(gè)臨時(shí)措施。做肥料這個(gè)片子上沒有介紹肥料應(yīng)用,環(huán)境方面的數(shù)據(jù)也沒有弄上來。南方的茶園、農(nóng)田土壤里,往水體里輸送流失的氮源污染。北方,更明顯的污染是霧霾,農(nóng)業(yè)對霧霾的貢獻(xiàn)也很大。在北方,一個(gè)是養(yǎng)殖業(yè)會排放大量氨氣。再一個(gè),北方的農(nóng)田偏堿性,尤其是氮肥,目前咱們這個(gè)種植模式,全靠使用化肥,化肥用量比較大,氮肥用下去,氨氮排放量特別大。因?yàn)楸狈较鄬碚f降雨少,流失到地表水沒有那么多,相當(dāng)于氨的排放,即霧霾的二次成因,它貢獻(xiàn)了一半。因?yàn)榘痹诳諝饫锸菈A性氣體,然后尾氣、化石燃料燃燒的這些酸性氣體在空氣里就發(fā)生中和反應(yīng),反應(yīng)以后形成鹽,鹽粒,PM2.5的小顆粒物。所以農(nóng)業(yè)系統(tǒng)的氨排放也非常的受重視?,F(xiàn)在我們要考慮一個(gè)是畜禽養(yǎng)殖糞便轉(zhuǎn)化過程中,盡量的讓氨能回收,少排放。再一個(gè),它生產(chǎn)的生物肥料,替代一部分化肥使用,這個(gè)結(jié)果也有了,還沒有發(fā)表文章。它對化肥使用氨的排放削減量可達(dá)60%到80%程度。目前,生物肥料,甚至是有機(jī)肥也有很好的作用,在環(huán)境效益方面,它有相對優(yōu)勢。
目前,我們生態(tài)中心主任歐陽也在做這個(gè),他們提供的理論對國家生態(tài)文明建設(shè)方面的支持,也是蠻大的。
在環(huán)境效益很好的情況下,怎么能把這個(gè)技術(shù),或者是這些模式,推廣下去,這個(gè)可能還是要從生態(tài)系統(tǒng)的角度來考慮,給國家一些政策方面的建議?,F(xiàn)在部分地區(qū)已在做試點(diǎn)了,包括最近,在河北的永清縣,他們是蔬菜種植基地。實(shí)際種植強(qiáng)度很高,有一些蔬菜,一年收八茬,每茬都要施肥的,可想而知這個(gè)污染物排放有多大,而且對菜的品質(zhì)也有一定的影響。他們有機(jī)肥用量很大,一畝地一年用五噸。至于花多少錢?他們說,是政府發(fā)的,不要錢,所以用量就大。
我認(rèn)為以上這些方法、模式對蔬菜品質(zhì)有益、老百姓有利,具有很好的環(huán)境、社會效益。但怎么讓企業(yè)去做這些事情?從市場的角度,目前還不是很好解決。所以,從政策層面,怎么能把環(huán)境效益轉(zhuǎn)化成經(jīng)濟(jì)效益,讓企業(yè)來實(shí)施。這也是我們在畜禽養(yǎng)殖,包括農(nóng)業(yè)污染這些方面的一些思考吧。
我的匯報(bào)就到這里,謝謝各位。
【討論與交流】
劉全友:現(xiàn)在開始討論。
孫飛翔:對這塊內(nèi)容有點(diǎn)接觸,這個(gè)材料總體的思路和技術(shù)是沒得說,是亮點(diǎn)。之前也參加過該項(xiàng)目的評審,這個(gè)“肯定”是一定的。
交代政策的背景,稍微有點(diǎn)偏差。第三段,黑臭水體問題,剛才我跟水司核實(shí)了一下,城市黑臭水體,主要是生活來源,跟咱們畜禽養(yǎng)殖不是特別直接。最后說以畜禽養(yǎng)殖為典型的整治已經(jīng)到了刻不容緩的地步。這個(gè)是農(nóng)村的,不是城市的。因?yàn)樵蹅儑页青l(xiāng)二元結(jié)構(gòu),是分開的,前面幾個(gè)關(guān)系不大。現(xiàn)在的農(nóng)村黑臭水體整治,也是限于水源安全這塊,和城市生活不一樣,它是兩碼事兒。
咱們中科院,最突出的技術(shù),應(yīng)該是三方面的亮點(diǎn),建議突出一下:
一個(gè)是處理后水質(zhì)的提高,剛才白老師介紹的時(shí)候也點(diǎn)到了,即使達(dá)標(biāo)處理,還是有一定差距。所以,現(xiàn)在好多地方也采取了達(dá)標(biāo)處理之后,進(jìn)入到一些當(dāng)?shù)乇容^大的河流、地表水之前,還會經(jīng)過人工濕地,這個(gè)數(shù)量和面積還是逐年提升的,都會過渡,然后再進(jìn)入到天然水體河流湖泊去。目前,建設(shè)質(zhì)量參差不齊,所以對水質(zhì)提升效果也是參差不齊。
第二,氮、磷其實(shí)是資源,進(jìn)入到地表水體反而成了污染,從技術(shù)角度是一個(gè)可以克服的事情,管理角度,是可以規(guī)避的事情。
第三,通過技術(shù),可以達(dá)到治理投資和管理投入的效果,高校、科學(xué)院也要和國家大政方針的落實(shí)緊密結(jié)合一下。結(jié)合,也是一個(gè)緊密的體現(xiàn)。
白志輝:您說得很對,我昨天晚上一看PPT,我就把黑臭水體那個(gè)片子就刪了,以前包括現(xiàn)在一直是做城市污水的。
孫飛翔:而且治理城市污水牽頭推動(dòng)是住建工作?,F(xiàn)在農(nóng)村重點(diǎn)是,一個(gè)是農(nóng)村環(huán)境和整治,另外一個(gè)是縣級以下水源地,打自配的井,飲水水質(zhì)提升這塊,目前還是農(nóng)村重點(diǎn)。養(yǎng)殖場外面挖一坑,算不算黑臭水體?或者說人家抽走,灌溉農(nóng)田了,人家自己用了。所以,這個(gè)很難界定。
盛學(xué)斌:現(xiàn)在污染的問題有目共睹,既有點(diǎn)上的,也有面上的。作為點(diǎn)上的一些大的養(yǎng)殖場,還有加工廠,這些都是大的東西。
現(xiàn)在的污染,水、土、氣。土壤的問題,我國從解放以來,隨著化肥用量的不斷增加,土壤的酸化程度在一步一步的下降。現(xiàn)在化肥用量在減少,農(nóng)村現(xiàn)在個(gè)體化,基本上不養(yǎng)殖了。所以,農(nóng)家肥料來源只有靠大的養(yǎng)殖場提供,但畢竟還是有限的。南方是酸性土壤,PH6左右,屬于亞熱帶,中部地區(qū)。到了華北這個(gè)地方,基本上是中性土壤,微堿性,再往內(nèi)蒙是栗鈣土了。但到東北,黑土,還有白漿土,又是酸性的,PH值6左右。
所以,我有一些想法,就是這個(gè)項(xiàng)目是很好的,第一個(gè)是切合國策,第二確實(shí)從根本上抓住了我們當(dāng)前這個(gè)大氣、水、土壤污染的要害問題。國家的國策上也做這方面的調(diào)整,出臺了好多的舉措。但我們既然作為一個(gè)模式,如果這個(gè)城市,它不是以工業(yè)為主導(dǎo)的,排出來的污染物主要是生活用水,包括我們一些化妝品的那些東西都排出去,主要是生活污水。這樣,我們利用微生物特長,怎么處理?
另外,剛才您說化工體,你這個(gè)微生物的種群又不一樣,要考慮地區(qū)、城市和工業(yè)布局的特點(diǎn),要分門別類,不能籠統(tǒng)而言。在不同區(qū)域,比如湖南,湖南就是湘潭、長沙、株洲這一帶,包括衡陽,這塊污染重一點(diǎn)。西南部,那個(gè)地方就相對輕一點(diǎn)。我們要根據(jù)一些大的區(qū)域,抓點(diǎn)、抓面。像北京這個(gè)地方,暖溫帶不一樣,那我怎么篩選有益的微生物種群,來作為我以后處理這些污染物的主要菌種?所以,我們要考慮城市的特點(diǎn),在研究不同的對象上,搞出不同的特色來。又如,華南、華中、華北、、西北是各不相同的。西北是干旱地區(qū),又怎么樣?做出不同的模式來。 把不同的區(qū)域,氣侯特點(diǎn),污染特點(diǎn),利用我的微生物,來做分類指導(dǎo)。
據(jù)中國農(nóng)大張福鎖教授統(tǒng)計(jì),我們從解放到現(xiàn)在的化肥用量很大,我和農(nóng)民交談,農(nóng)民說你們城市人吃的都是化肥和農(nóng)藥,盡管國家采取各種管控措施。但污染依然在,所以我們得了好多病,說是富貴病,其實(shí)是污染病。
這個(gè)項(xiàng)目,我很感興趣,時(shí)間有限。下去我們可以座談,談一些個(gè)人意見,互相啟發(fā)一下。我建議,一個(gè)是大趨勢上考慮一下,因?yàn)闅夂畈灰粯?,土壤類型不一樣,酸化程度不一樣,微生物的種群也不一樣,要抓住我們的特色。比如華北這個(gè)地方,是中性土壤,我也抓城市和農(nóng)村,點(diǎn)和面,有特色,非常有分量,你可以報(bào)國家大計(jì)劃。要搞出來,很有現(xiàn)實(shí)意義,也有負(fù)面意義。這個(gè)項(xiàng)目很重要,可做的地方太多了。
桂文莊:這個(gè)題目強(qiáng)調(diào)的生態(tài)問題,關(guān)鍵是用生物技術(shù)處理畜禽糞便,用微生物、狐尾藻這一類的東西來處理廢水,然后微生物發(fā)酵處理糞便。你講到畜禽糞污處理技術(shù)幾個(gè)方面的應(yīng)用。從搞學(xué)術(shù)來說,確實(shí)是從技術(shù)出發(fā)。剛才盛老師說的,你還要從應(yīng)用出發(fā),應(yīng)用來牽引,不同的特點(diǎn)需要你不同的技術(shù),你的技術(shù)怎么適應(yīng)它?其實(shí)是兩方面,一方面要用應(yīng)用需求來牽引需求;另一方面,我們還要從技術(shù)發(fā)展本身的邏輯和思路來看,我的生物技術(shù),我的微生物,在哪些廢水,或者其它的廢物資源上,能起什么樣的作用?你應(yīng)該有一系列的方案,針對哪些廢水、哪些廢棄物,可以弄個(gè)譜系出來,像元素周期表一樣的,你們生態(tài)中心是可以做這個(gè)事兒的。我覺得從這個(gè)角度來說,學(xué)術(shù)發(fā)展本身的邏輯上,也可以考慮,要在系統(tǒng)理論發(fā)展上來,解決我們的生物處理技術(shù)。
盛學(xué)斌:可以寫專著啊,搞出來,每個(gè)方面都有特色,最后指導(dǎo)實(shí)際應(yīng)用,而且用的效果非常好,人家就認(rèn)可,認(rèn)可以后,人家就自動(dòng)的找你,你就是熱門貨。推廣了,在農(nóng)業(yè)上就會取得巨大的效果。
孫飛翔:糞污處理技術(shù),還可以強(qiáng)調(diào)一下它相對于化肥的安全性。咱們要強(qiáng)調(diào)一下,有機(jī)肥相對于化肥的安全性,是很重要的。前幾年化肥零增長計(jì)劃,實(shí)際上下一步可以達(dá)到化肥負(fù)增長。
桂文莊:農(nóng)村要減少化肥,要增加有機(jī)肥。有機(jī)肥誰給頂上???現(xiàn)在農(nóng)村養(yǎng)殖業(yè)是發(fā)展大型的養(yǎng)殖場。那么,它你能生產(chǎn)多少有機(jī)肥料來供應(yīng)農(nóng)村的需求,這個(gè)有沒有計(jì)算過?
王貴海:化肥的使用,是個(gè)雙刃劍。中國農(nóng)業(yè)的發(fā)展得益于化肥,中國的畝產(chǎn)高產(chǎn)是靠化肥頂?shù)?。但化肥帶來的問題又挺大,而且的確嚴(yán)重得不能再嚴(yán)重了,而目前化肥又是不可能取代的?;手苯訋淼奈:κ撬w、土壤的污染,使之富營養(yǎng)化。現(xiàn)在解決的辦法,就是盡量減少化肥的使用和提高化肥使用效率。要在怎么樣在吸收、利用氮肥磷肥的使用效率方面下功夫。在如何通過農(nóng)田田間管理和改良作物使其提高氮磷利用效率等方面著手。所以農(nóng)家肥的使用,僅能夠解決一個(gè)方面,或者逐漸增加。農(nóng)民還是喜歡用化肥,多使用一些,產(chǎn)量就上去一些。
這個(gè)項(xiàng)目里,我感覺解決水污染可能更為關(guān)鍵。因?yàn)楣腆w糞部分完全可以資源化,通過微生物發(fā)酵,可以變成很好的肥料,裝成袋子,物流出去。這個(gè)技術(shù)用生物轉(zhuǎn)化的辦法,是可以很好解決的。但污水處理,農(nóng)村比較早發(fā)展沼氣利用,解決了一定問題?,F(xiàn)在隨著能源結(jié)構(gòu)的改變,除了偏僻的農(nóng)村,其它都是用電了。但現(xiàn)在污水的處理關(guān)系到環(huán)境、生態(tài),關(guān)系到國家水體,最后都到流域去了。這不僅是過量氮磷的問題,現(xiàn)在還有關(guān)養(yǎng)殖瘦肉精、抗生素等物質(zhì)對水體的污染問題。
今天介紹的技術(shù),我覺得挺好。一個(gè)是用微生物膜的技術(shù),用微生物膜凈化,再一個(gè)是高效的水草兩個(gè)凈化,這樣可以更加完善。所以污水處理,我認(rèn)為在目前的糞污的處理當(dāng)中,是重中之重。
我們對環(huán)境的這個(gè)要求,可能主要是排污。而排污,很大部分是不合格的,你怎么辦?給它關(guān)閉?小的可以。國家總得有一定規(guī)模的養(yǎng)殖業(yè)吧!所以,我們要針對養(yǎng)殖業(yè)的不同模式的需求來研究。牛廠、豬場的處理方式各有不同。雞、鴨都不一樣,那么規(guī)模大小也不一樣。我們已經(jīng)對不同規(guī)模的處理模式,都有一個(gè)大、中、小規(guī)模問題。但是可能結(jié)合不同類型不同規(guī)模的養(yǎng)殖場,也有不同的治理方法,將來被國家認(rèn)定的集約化治理技術(shù),也可硬性要求采用這個(gè)技術(shù)和標(biāo)準(zhǔn)?,F(xiàn)在我們把這個(gè)技術(shù)能夠集成、標(biāo)準(zhǔn)化,變成一個(gè)國家可以推廣采用的技術(shù),還是要規(guī)范為好。
要有環(huán)境的理念?,F(xiàn)在習(xí)近平總書記講綠水青山。現(xiàn)在我們針對畜禽糞污處理,要針對養(yǎng)殖產(chǎn)業(yè)的發(fā)展,隨著人類生活水平的提高,食肉量的增加,特別是牛肉,中國的養(yǎng)殖業(yè)將會有很大的發(fā)展,應(yīng)用技術(shù)的需求也會越來越大。所以,這個(gè)工作帶有很重要的環(huán)境意義、生態(tài)意義,而且對資源的綜合利用,也非常好,應(yīng)該是一個(gè)非常好的模式。
馬惠昌:前幾年我回了趟老家,魯西南,黃牛是專供香港的。但我轉(zhuǎn)了幾個(gè)村子,沒有一戶養(yǎng)黃牛、羊的。過去一家養(yǎng)一只羊、養(yǎng)雞的都沒有了。因?yàn)橥寥榔茐亩紱]有草了。他們生活還挺不錯(cuò)的,比如說春天來了,花一點(diǎn)錢,買點(diǎn)化肥,讓機(jī)器撒在田里,再花點(diǎn)錢,拖拉機(jī)把種子下到地里頭,莊稼不長草,就等著收,一直把糧食送到家里去。
我小的時(shí)候,魯西南一畝地,最多產(chǎn)一百斤糧食,現(xiàn)在最多產(chǎn)一千斤小麥,還可以再產(chǎn)一千斤玉米,又不用除草、又不用收割,也不用養(yǎng)家畜之類的,你說你搞農(nóng)村這些糞便的處理,其實(shí)沒什么東西了,跟過去不一樣了。
王貴海:幾百頭上千頭是少的,都是規(guī)?;B(yǎng)殖。他們糞便、污水的處理,更成問題了。規(guī)模國家控制,就是幾百頭的養(yǎng)殖問題嚴(yán)重。
盛學(xué)斌:咱們現(xiàn)在談的都是規(guī)模性的,不是一家一戶的。
王貴海:我認(rèn)為要調(diào)查研究,農(nóng)村上百頭、上千頭的有多少?問題是,上規(guī)模的、上萬的都有人管,幾百上千的沒人管。所以,我們要關(guān)注農(nóng)村發(fā)展,跟脫貧結(jié)合,幾百上千頭你不管的話,源頭都在那啊,他們對市場也有貢獻(xiàn)啊,但農(nóng)村幾百頭的污染問題的解決就麻煩了。小型養(yǎng)殖戶不好管,糞便都是直排。怎么辦啊?所以對這些小型的養(yǎng)殖,給他一個(gè)治理模式,還是挺好的。真正有錢的地方,像北京、上海等發(fā)達(dá)地問題不大。所以主要還是貧困的山區(qū)、貧困的村,農(nóng)民致富,養(yǎng)豬是一條路。
劉雨佳:我是做企業(yè)、做流域的。剛才各位老師說的城市的黑臭水體,環(huán)境改善,我們都有接觸,尤其是近兩年提出青山綠水,其中一個(gè)重大風(fēng)險(xiǎn)咱們不說了,還一個(gè)治污、鄉(xiāng)村振興的攻堅(jiān)戰(zhàn)?,F(xiàn)在咱們題目,契合得非常好,企業(yè)角度有需求。剛才老師也提到了,這次環(huán)保部將很多不成規(guī)模的、小的這種養(yǎng)殖場,以非常粗暴的方式,就關(guān)、停、合并了,實(shí)際上這里邊是有問題的,就是大家說的一刀切的問題。但是,現(xiàn)在這個(gè)技術(shù),實(shí)際上原來這塊是一個(gè)模糊地帶,沒人管,大的肯定有人管,小的呢,監(jiān)管,三年目標(biāo)、兩年目標(biāo),消除黑臭。從政府角度來說,關(guān)了最好。 現(xiàn)在這種情況,肯定是要結(jié)合起來的。其實(shí)剛才說到這里面有個(gè)非常典型的,包括農(nóng)業(yè)化肥的問題。還有剛才說到的經(jīng)濟(jì)問題,它整個(gè)山上一萬多畝地,全是秧苗,畝產(chǎn)經(jīng)濟(jì)價(jià)值兩到三萬元,你讓它說施肥,絕對不可能的,不能接受的,怎么辦呢?我們也要做啊,因?yàn)槿牒际歉粻I養(yǎng)化嘛,湖泊很危險(xiǎn)的。
我們企業(yè)提出一個(gè)“投資一體化,帶動(dòng)治理一體化”的想法,我們簽協(xié)議,落到州里、縣里。我們四個(gè)湖,打包起來做。實(shí)際上企業(yè)非常有迫切的需求,如何把農(nóng)業(yè)種植結(jié)構(gòu)與土地,化肥的施用、湖河的生態(tài)化、鄉(xiāng)村振興、美麗鄉(xiāng)村相結(jié)合,我們都做出來了。不僅僅是一個(gè)鋼筋混凝土池子,也不是鐵罐子,我們是要采取跟自然生態(tài)環(huán)境相協(xié)調(diào)的方式。白老師他們這個(gè)課題,跟我們需求完全契合呼應(yīng)上了。下一步我們想跟中科院多學(xué)習(xí),多溝通,如果有機(jī)會的話,可在我們工程產(chǎn)業(yè)化上做推廣。
賀兆旗:我可能有點(diǎn)外行。這個(gè)畜禽糞污其實(shí)是很好處理的。因?yàn)樗统鞘欣幚聿灰粯?,沒有垃圾那么復(fù)雜。在你們的方案中,要把糞便分成兩種來處理,其中有沼氣池,還有異位發(fā)酵床。這兩個(gè)東西為何要把它分開呢?如果干濕混和處理,產(chǎn)生沼氣后的固體回來做肥料就可以了。
盛學(xué)斌:現(xiàn)在北京郊區(qū)都燒煤氣,樹枝、草都不讓燒了。
賀兆旗:現(xiàn)在沼氣池沒有達(dá)到規(guī)模,養(yǎng)殖場達(dá)到一萬頭,一天要處理一百多噸,兩百噸,這個(gè)規(guī)模很大的。所以,你把沼氣、糞便分成兩種來處理,最后處理過后,還有廢水,還有達(dá)標(biāo)排放問題。
現(xiàn)在這個(gè)達(dá)標(biāo)排放根本就不是零排放?,F(xiàn)在問題是沼氣池處理怎么達(dá)到零排放?這個(gè)關(guān)鍵問題就是沼氣怎么做?現(xiàn)在最好的做法,就是高溫化,40到50度之間。這樣處理過后的廢水,都是干凈的,就沒有了,就沒有達(dá)標(biāo)排放的問題了?,F(xiàn)在廢水的處理,沼氣,廢水的量大,怎么產(chǎn)生呢?就是重新混干的過程中,大量用了清水,這一個(gè)是要改掉的。怎么可以發(fā)生呢?就是沼氣產(chǎn)生沼泥,沼泥是非常干凈的,把細(xì)菌全部殺死了,可以把它放回去,重新的使用。所以說,高溫化學(xué)產(chǎn)生的結(jié)果,就是達(dá)到清潔的糞便和沼氣,而且沼氣呢,可以反復(fù)去用、無限去用的,這就沒有廢水的問題了,這個(gè)才是真正的零排放了。
馬惠昌:那你這個(gè)50度怎么辦?
賀兆旗:對,這個(gè)能源怎么來?一個(gè)是利用產(chǎn)生沼氣的化學(xué)過程中產(chǎn)生的熱,要產(chǎn)生出來的沼泥是50度,關(guān)鍵就在怎么用它夾載低溫的沼泥。另一個(gè)來源,就是利用太陽能。其實(shí)我們用第一個(gè)就夠了。因?yàn)檎託夂芏?,它直接在生產(chǎn)過程中要發(fā)熱,只要我們把熱量回收起來,直接再產(chǎn)生5度到10度的溫度就行了。
我看你的講稿,用的有膜技術(shù),用在什么地方的?膜是很好的技術(shù),但是這個(gè)膜是怎么做的?有保密嗎?你能不能介紹一下?
白志輝:這實(shí)際上就是剛才老師說的集成一些技術(shù),這個(gè)不是我們的重點(diǎn),我們的核心在模式上,根據(jù)它的現(xiàn)場情況而定。老的養(yǎng)殖場,沼氣池基本上已經(jīng)有了。但是它排出來的沼液濃度太大了,所以,要根據(jù)它的場地和周邊農(nóng)田可利用的情況,如果沒有很好的空間,那就把污水處理的單元給它組合起來用,那膜就是相當(dāng)于讓水質(zhì)提升很好的技術(shù)。但現(xiàn)在主要是用在生活污水上,養(yǎng)殖上用的卻很少。
從養(yǎng)殖廢水,如果處理達(dá)標(biāo)排放,成本確實(shí)挺高。那我們所說的資源化也好,零排放也好,我覺得正確的說法還是資源化利用。比如說農(nóng)村新建的,不是說都可以,有些地方要求,建一個(gè)養(yǎng)殖場,你必須留有足夠消納這些營養(yǎng)物的農(nóng)田,才讓你建。所以,這些資源化的技術(shù)就好用了。但大部分是以前已經(jīng)建的,沒有那么多的農(nóng)田,根據(jù)當(dāng)?shù)氐那闆r,然后用一些技術(shù)的集成,需要占地小的、強(qiáng)度大的處理技術(shù)都能用上??傊?,控制污染是首要的,能資源化利用的一部分,就是資源化利用。
實(shí)際上沼液出來的東西,跟水完全是兩回事,不能叫水,或者叫沼液,或者叫廢液。這種濃度的液體,在城市垃圾里甚至歸到固廢里了,濃度確實(shí)太大。所以,后面我們一直在做的,就是怎么把養(yǎng)分資源化利用。如果直接當(dāng)水灌到莊稼地,作物完全不能生長。當(dāng)肥料,要加工處理,效果更好一點(diǎn),還是把它做成肥料來用。
生物菌劑的這些產(chǎn)品,因?yàn)楫?dāng)?shù)氐南{容量不夠,沒有那么大的農(nóng)田,怎么辦?我們做成高質(zhì)化的產(chǎn)品,運(yùn)到遠(yuǎn)處用。如果是當(dāng)水,或者稀釋以后,往遠(yuǎn)處運(yùn),成本太高了。
所以,根據(jù)它的問題,采取技術(shù)在這兒組合,在技術(shù)組合的過程中,還有能更提高一步的,以微生物技術(shù)為主的,包括植物和微生物的協(xié)同,這方面充分利用起來。這是我們比較成熟的技術(shù),養(yǎng)殖場它還是成本太高。
桂文莊:你的處理方法,都是先把糞便處理成固態(tài)液態(tài)分開的?
白志輝:現(xiàn)在不分開的也有。但它的沼液仍然不是水,仍然是很濃很濃的液體。說它是水吧,牽強(qiáng),也可以叫污水,廢水。但它里面的濃度太大了。因?yàn)楫?dāng)農(nóng)田灌溉用水的話,像COD排放指標(biāo),市政污水,生活污水,基本上COD不怎么控制,稍微降解,可達(dá)到200,氮磷不控制,那沼液就不行了,寸草不生。
賀兆旗:現(xiàn)在農(nóng)田灌溉,這個(gè)沼液根本就不夠用。
白志輝:您說的全國的農(nóng)田用沼液灌溉肯定是不夠的。但它面臨什么呢?以前有的養(yǎng)殖場,沒有考慮這個(gè)問題,它建的奇大無比,沒有可用?,F(xiàn)在新建的,就要求你必須流轉(zhuǎn)這么大的農(nóng)田,種養(yǎng)一體化,否則,是不讓你新建養(yǎng)殖場的。但以前沒有,空間是完全不夠的,不匹配的。
賀兆旗:現(xiàn)在這個(gè)輸送,你可以送到很遠(yuǎn)很遠(yuǎn)的地方去,都可以。還可以用管道。
桂文莊:我的理解,你分開的目的,有機(jī)肥,可以做高質(zhì)量的有機(jī)肥,然后廢水處理,就地使用了。
白志輝:更濃的液體。比如說糞便處理以后,底下的沉淀物,也是泵抽的,就是連渣子帶水,更濃的,它異位發(fā)酵床,除了把沼渣形成有機(jī)肥以外,它有一個(gè)蒸發(fā)水分的作用,也是把液體蒸發(fā)掉一部分,只是說更濃的液體。
桂文莊:第二個(gè),你這個(gè)后處理也比較容易。
白志輝:因?yàn)榛旧犀F(xiàn)有的已經(jīng)建了,你說拆了重建,他也不太樂意。因?yàn)轲B(yǎng)殖企業(yè),還是對污染治理的這個(gè)投入是非常謹(jǐn)慎的,他不愿意推倒重來。以前,要求也規(guī)范,糞污,必須有沼氣池來處理,實(shí)際上是污水處理系統(tǒng),有的養(yǎng)殖企業(yè),把沼氣回收了,作為加熱的能源,有的就直接排了,所以還是污水處理的單元問題。
桂文莊:沼氣回來本身可用,減少它自己的能源消耗。
白志輝:是的。
殷興軍:在你這個(gè)展望里,一噸廢水有0.55公斤的二氧化碳,每年向環(huán)境中排放二氧化碳的量,相當(dāng)于18億輛汽車一年的排放量,怎么解決這個(gè)問題?18億輛汽車,中國了不起也就是8億輛汽車。
白志輝:這個(gè)是說,如果把廢水處理達(dá)標(biāo)排放了,所需要消耗的電能。
殷興軍:能夠排放是我國規(guī)定的標(biāo)準(zhǔn),我國規(guī)定的標(biāo)準(zhǔn)太低了,很松,不嚴(yán)。
白志輝:僅作為水處理不合適,應(yīng)該是資源化利用。養(yǎng)殖的廢水,處理達(dá)標(biāo)排放,需要消耗很多能源。即這個(gè)套路是臨時(shí)的措施,得不償失,或者是成本太高。所以,我們今后的發(fā)展還是要把這個(gè)糞污里的資源采取回收利用這個(gè)思路來。
莫漢宏:你這個(gè)技術(shù)好幾個(gè)地方都用了,也舉了例子。我想問一下成本,假如說我作為企業(yè),我用了你的技術(shù),我要投多少錢?資源化,不是資源,是資源化,你可能是一個(gè),投入跟輸出,也可能能抵消,你能不能把這個(gè)成本介紹一下?
白志輝:后面沒寫清楚,相當(dāng)于是一個(gè)問題的延伸。污水處理的成本很高。18億輛汽車的排放,如資源化的話,這些東西可以規(guī)避一些,比如說在種狐尾藻,它生產(chǎn)這個(gè)蛋白質(zhì)量,一畝地,相當(dāng)于十畝的玉米。它的產(chǎn)出,應(yīng)該比投入要大,這是資源化路線。但是得有條件,比如說你這個(gè)養(yǎng)殖企業(yè),周圍得有地可以用,才能資源化,實(shí)際上資源化后它是有經(jīng)濟(jì)效益的,一畝狐尾藻相當(dāng)于十畝玉米,可做飼料。
莫漢宏:上規(guī)模的,什么是上規(guī)模我也不太了解,假如說一萬頭的豬,實(shí)現(xiàn)你一套技術(shù),我廠家要投多少錢?
白志輝:就是不同規(guī)模的,有地方的,還有沒地方的,還有地方有點(diǎn)欠缺的,三種模式。一萬頭豬,相當(dāng)于完全是污水處理,一年的,包括建設(shè)、運(yùn)營,有這么幾個(gè)數(shù)字吧,幾種模式。
第二個(gè)模式就是有面積的話,相對來說,面積越大,成本越低。如現(xiàn)有的老的養(yǎng)殖企業(yè)相對來說,還沒有涉及到,還都不是完全的。那新建的,必須流轉(zhuǎn)足夠多的農(nóng)田,才能使用。而目前只是依據(jù)老的養(yǎng)殖企業(yè),就它周邊的現(xiàn)有的可利用的土地面積來做的一個(gè)規(guī)劃。
莫漢宏:這個(gè)資料上沒提到。所以你剛才說的都是一般性的東西,比如說上萬頭,我要投多少錢?最后我能否收回來?也許您這個(gè)資料已準(zhǔn)備得很充分。
白志輝:介紹的是有點(diǎn)簡單。這里都是對于老的已有的養(yǎng)殖場,不是說新建的。這里說的是完全資源化的那種模式,還是強(qiáng)調(diào)包括處理和資源化的結(jié)合。比如說一萬頭的規(guī)模,完全是在工業(yè)污水處理工藝的情況下,建設(shè)成本500多萬元。如果有地,我們可做一個(gè)濕地系統(tǒng),它就可以投資300多萬元。濕地不夠大,這種就是400多萬投資成本。建設(shè)成本,加上運(yùn)行費(fèi),純污水處理,應(yīng)該是每年有60萬元的運(yùn)行費(fèi),如果好一點(diǎn)的話,相當(dāng)于30多萬的運(yùn)行成本,這里指的大都是已有的養(yǎng)殖場。如果新建,那就不一樣了,新建的你有足夠消納糞污的土地,如果采用生物技術(shù),轉(zhuǎn)化成很好的肥料,包括液體的、固體的,所生產(chǎn)出來的農(nóng)產(chǎn)品相對來說,質(zhì)量可以控制得更好一些。
桂文莊:有一個(gè)問題,假定萬頭存欄豬,處理模式二,需要面積25000平方米,建設(shè)及運(yùn)行費(fèi)加一起425萬元。你資源化之后的資源產(chǎn)出能夠抵消多少?
白志輝:可以算。但怎么實(shí)現(xiàn)它,是另一回事兒。比如說,咱們以玉米的產(chǎn)飼料為例,一畝狐尾藻,產(chǎn)蛋白量做飼料的話,相當(dāng)于十畝玉米的產(chǎn)量,根據(jù)玉米蛋白的含量,可以折算一下它的相當(dāng)于多少蛋白的價(jià)值。 但這個(gè)數(shù),跟后面的一些運(yùn)營的、銷售的等都有關(guān)系。因?yàn)檫@個(gè)數(shù)會有一個(gè)波動(dòng),所以,相對來說,它波動(dòng)比較大,就沒有細(xì)算過,應(yīng)該肯定是有盈利的。
桂文莊:它的產(chǎn)出,一個(gè)是有機(jī)肥,一個(gè)是狐尾藻產(chǎn)生的飼料。除此,還有什么東西?可能還有水回收再利用的,因?yàn)闆_洗豬圈不需用外面引水,可以回收一部分水循環(huán)再利用。給企業(yè)能夠帶來效益。我建議你們還是要算一算,便于說服人家來使用。
何遠(yuǎn)光:我給你算了一下,一頭豬500塊,一萬頭500萬。但你投資運(yùn)行430萬元,你賣,還有成本,所以,利潤并不高。你投資,肯定是一兩年是不行的。所以,一般來講,我一年只能賣500萬,我一次投入這么多干這個(gè)事兒,我多少年回收成本? 所以,還是算一下,就是要吸引人家來用的。
莫漢宏:按你剛才那么算,他就白養(yǎng)了。
盛學(xué)斌:三個(gè)效益,經(jīng)濟(jì)效益是第一的。
何遠(yuǎn)光:我問一個(gè)問題,你到底有什么創(chuàng)新點(diǎn)?我沒有聽清楚,就是你在處理這個(gè)糞污問題上你是講了很多,生物辦法、菌的辦法,可以發(fā)表??晌覀冏约旱木詈?,跟世界其它國家比我們是最先進(jìn)的,但聽起來好像還是沒過癮似的。
白志輝:這里的關(guān)鍵,我們是一個(gè)技術(shù)的集成。在應(yīng)用過程中,我說的可能有點(diǎn)亂,實(shí)際上已涉及到很多方方面面了。
目前已有的技術(shù),存在一些特點(diǎn),比如說作為生物肥料、有機(jī)肥,如推廣的話是一個(gè)很好的東西。但是剛才說到,它沒有空間的時(shí)候,你這個(gè)有機(jī)肥,往遠(yuǎn)處運(yùn),成本又上去了,又不現(xiàn)實(shí)了。所以,我們把有機(jī)肥做成生物有機(jī)肥,要篩選,也是從自然環(huán)境、農(nóng)田、植物的根基中,篩選了高效的植物促生菌,肥效提高了,價(jià)值也提高了,即便當(dāng)?shù)貨]有消納,稍微運(yùn)得遠(yuǎn)一點(diǎn),還是有經(jīng)濟(jì)效益的。
一個(gè)是微生物肥料方面,研究基礎(chǔ)比較好,面臨市場化的問題。要應(yīng)盡量的讓經(jīng)濟(jì)效益來推動(dòng)此工作。這也是我們的中心。目前,我們研究的環(huán)境效益更深入一些。生物肥料使用以后,跟普通的有機(jī)肥相比,它減少了多少氨的排放,減少了多少農(nóng)田化肥的流失等。在習(xí)總書記的綠水青山的理論里頭,我們也可以算出來生態(tài)服務(wù)的效益,這個(gè)生態(tài)服務(wù)的價(jià)值往往更大,這些可能就需要國家的層面,制訂一些市場化機(jī)制,或制訂一些政策方面的影響,可能就更有意義些。
在經(jīng)濟(jì)、環(huán)境、社會效益方面,我們的有機(jī)肥,一畝地用五噸,成本很高。我們不需要花錢,這是政府發(fā)的,這對農(nóng)田有一個(gè)很好的修復(fù)與改善作用。所以,我們還是關(guān)注它的環(huán)境和社會效益多一些,而經(jīng)濟(jì)效益提得就相對少一些。
黃德濟(jì):你選的菌劑有什么特色?你那個(gè)植物、微生物的復(fù)合系統(tǒng)是好的方法。即物理法、化學(xué)法,它的經(jīng)濟(jì),還有它需要消耗的能量,還有成本,一下都提上去了??删兔磕昴敲创蟮膬r(jià)值,你要采取哪樣的方法?如微生物的方法,它符合大自然的規(guī)律,成本就降下來了。選擇合適的菌,效率比較高,降解快,這就是你的特色,你的創(chuàng)新點(diǎn)。所以,你應(yīng)該在這方面下工夫,要講得更明確一些。另外,你們應(yīng)該和退下來做這方面工作的老同志進(jìn)行聯(lián)系,比如說賀老師,他在這方面有些想法,他在家里天天研究這方面,他有合理的建議,又不收費(fèi),挺好的事情。
盛學(xué)斌:老先生們提的建議,對于下一步完善和制訂方向有很好的參考價(jià)值。如你這個(gè)模式,我現(xiàn)在拿來用,用在什么地方?能不能引起政府的重視?這就是硬碰硬了。在華北地區(qū)城市也好,養(yǎng)殖場也好,要敢說這種話。有理論意義、指導(dǎo)意義,更有戰(zhàn)略意義,會引起更多人的認(rèn)可。
桂文莊:我提兩點(diǎn)意見,這個(gè)報(bào)告,你可以從兩個(gè)方面說,現(xiàn)在混在一起了。一個(gè),你就著重講你的生物技術(shù)、創(chuàng)新點(diǎn),有什么好處,將來用到什么地方,報(bào)告這樣做,很精彩;第二個(gè),你針對你的問題,你的系統(tǒng)要集成哪些技術(shù),哪些是創(chuàng)新的,經(jīng)濟(jì)效益怎么樣?最后達(dá)到什么效果?這套思路,又是一套講法。如果你講集成系統(tǒng)的話,我們不能光講生物技術(shù),生物技術(shù)只是一部分,還要講到別的東西,剛才很多別的想法在里頭,還有很多別的處理方法,所以你集成的時(shí)候,就是挑各種各樣的最適合的技術(shù),既適合當(dāng)?shù)厍闆r,又成本低廉,效益又好,你要達(dá)到這樣的效果,就是講集成技術(shù)的辦法。
李祖明:我提個(gè)建議。包括畜禽糞污里可能存在的抗生素,我們用了之后,怎么能無害?能不能采用不同的微生物進(jìn)行降解,對不同的廢棄物,采用不同的菌,分解抗生素,使之無害化。另外包括狐尾藻處理這些廢水,我想也是無害的問題,過程中的廢水,是不是存在剛才專家提到的這些,如果存在這些,能不能分離一些菌,然后使它達(dá)到無害的狀態(tài),既要保證它資源化,還有無害化,不要造成二次污染。
利用各種菌類、培養(yǎng)菌種等技術(shù),逐漸形成了“農(nóng)業(yè)種、養(yǎng)、加廢棄物高值化利用”的技術(shù)思路,很好。
劉全友:時(shí)間到了,今天的發(fā)言、討論非常熱烈。說明我們的選題具有社會的關(guān)注度和經(jīng)濟(jì)建設(shè)的實(shí)用性。
一、報(bào)告的前瞻性在哪里?主要利用理化、各種菌類,包括培養(yǎng)不同菌種等技術(shù)手段,通過該種、養(yǎng)、加集成技術(shù)實(shí)現(xiàn)畜禽養(yǎng)殖糞污的氮磷控制、化肥減施以及農(nóng)藥減量。在這個(gè)系統(tǒng)里,優(yōu)化生物功能,利用功能微生物菌劑來強(qiáng)化系統(tǒng),將農(nóng)產(chǎn)品加工作為它的生產(chǎn)原料,在消納這個(gè)污染物的同時(shí),生產(chǎn)一些環(huán)境友好的產(chǎn)品,這些菌劑又反過來強(qiáng)化污染物的轉(zhuǎn)化成資源化的思路。實(shí)現(xiàn)不是排放,而是回收、利用為目標(biāo)的路線,從而實(shí)現(xiàn)經(jīng)濟(jì)、社會、生態(tài)效益的良性循環(huán)。
二、創(chuàng)新點(diǎn)。最大亮點(diǎn)是強(qiáng)調(diào)了系統(tǒng)性。將一個(gè)規(guī)模化養(yǎng)殖場為一個(gè)單元,而將糞污排放(水、渣、氣、有機(jī)物等)、治理方法、農(nóng)田消納(包括濕地)、植物吸收等作為元素,組合成一個(gè)系統(tǒng)進(jìn)行考慮,即水、土、氣三大介質(zhì)中的污變?yōu)閷?,真正?shí)現(xiàn)良性循環(huán)的技術(shù)路線。以克服傳統(tǒng)治理方法中的小、亂、差,單純治了廠房,污染了水、土、氣的弊病 。體現(xiàn)了通盤考慮、綜合治理、回收利用的基本原則。
我在上世紀(jì)80年代做過海河流域C、N、S、P的循環(huán)課題,其中有水、土、氣三大介質(zhì),如不講系統(tǒng)性,就很難計(jì)算元素的濃度、在三大介質(zhì)中的通量、平衡等。所以,單獨(dú)來衡量如CO2,排放、平衡等就更難。因此,生物培養(yǎng)技術(shù),利用治理排污,反促種+養(yǎng)+加綜合利用與發(fā)展,才能滿足我國肉類的、經(jīng)濟(jì)的、環(huán)境發(fā)展的需求。
這次沙龍活動(dòng)非常好,各位領(lǐng)導(dǎo)、專家、企業(yè)都來了,對題目的亮點(diǎn)進(jìn)行了肯定。也提了些看法,尤其是院部委、高等院校、企業(yè)、老專家提出的具體問題,為我們下去多加交流,不斷完善提供了基礎(chǔ)。

